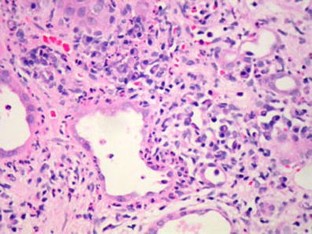

Abstract
We describe two adolescents who presented with end-stage renal failure and clinical features suggestive of Sjögren’s syndrome (SS). They both demonstrated severe, chronic, tubulointerstitial inflammation on renal biopsy, high-titre antinuclear antibodies, high immunoglobulin A and G concentrations, positive anti-SSA and anti-SSB antibodies, and negative anti-double-stranded DNA antibodies. One had subjective and objective evidence of the sicca complex (dry eyes and/or dry mouth) and fulfilled the commonly accepted SS consensus criteria. The other showed no evidence of the sicca complex but fulfilled modified criteria for juvenile SS. SS may be underrecognised as a cause of end-stage renal failure in childhood.

References
Vitali C, Bombardieri S, Jonsson R, Moutsopoulos HM, Alexander EL, Carsons SE, Daniels TE, Fox PC, Fox RI, Kassan SS, Pillemer SR, Talal N, Weisman MH (2002) Classification criteria for Sjogren’s syndrome: a revised version of the European criteria proposed by the American-European Consensus Group. Ann Rheum Dis 61:554–558
Houghton K, Malleson P, Cabral D, Petty R, Tucker L (2005) Primary Sjogren’s syndrome in children and adolescents: are proposed diagnostic criteria applicable? J Rheumatol 32:2225–2232
Bartunkova J, Sediva A, Vencovsky J, Tesar V (1999) Primary Sjogren’s syndrome in children and adolescents: proposal for diagnostic criteria. Clin Exp Rheumatol 17:381–386
Bossini N, Savoldi S, Franceschini F, Mombelloni S, Baronio M, Cavazzana I., Viola BF, Valzorio B, Mazzucchelli C, Cattaneo R, Scolari F, Maiorca R (2001) Clinical and morphological features of kidney involvement in primary Sjogren’s syndrome. Nephrol Dial Transplant 16:2328–2336
Goules A, Masouridi S, Tzioufas AG, Ioannidis JP, Skopouli FN, Moutsopoulos HM (2000) Clinically significant and biopsy-documented renal involvement in primary Sjogren syndrome. Medicine 79:241–249
Ohlsson V, Strike H, James-Ellison M, Tizard EJ, Ramanan AV (2006) Renal tubular acidosis, arthritis and autoantibodies: primary Sjogren’s syndrome in childhood. Rheumatology 45:238–240
Pessler F, Emery H, Dai L, Wu YM, Monash B, Cron RQ, Pradhan M (2006) The spectrum of renal tubular acidosis in paediatric Sjogren syndrome. Rheumatology 45:85–91
Moutsopoulos HM, Cledes J, Skopoul, FN, Elisaf M, Youinou P (1991) Nephrocalcinosis in Sjogren’s syndrome: a late sequela of renal tubular acidosis. J Intern Med 230:187–191
Koenig M, Hacini J, Thibaudin D, Rousset H, Cathebras P (2004) Distal renal tubular acidosis ten years before Sjogren’s syndrome. Rev Med Interne 25:764–766
Eriksson P, Denneberg T, Enestrom S, Johansson B, Lindstrom F, Skogh T (1996) Urolithiasis and distal renal tubular acidosis preceding primary Sjogren’s syndrome: a retrospective study 5–53 years after the presentation of urolithiasis. J Intern Med 239:483–488
Palcoux JB, Janin-Mercier A, Campagne D, Fonck Y, Betail G (1984) Sjogren syndrome and lupus erythematosus nephritis. Arch Dis Child 59:175–177
Zufferey P, Meyer OC, Bourgeois P, Vayssairat M, Kahn MF (1995) Primary systemic Sjogren syndrome (SS) preceding systemic lupus erythematosus: a retrospective study of 4 cases in a cohort of 55 SS patients. Lupus 4:23–27
Brickman CM, Tsokos GC, Balow JE, Lawley TJ, Santaella M, Hammer CH, Frank MM (1986) Immunoregulatory disorders associated with hereditary angioedema. I. Clinical manifestations of autoimmune disease. J Allergy Clin Immunol 77:749–757
Suzuki Y, Hinoshita F, Yokoyama K, Katori H, Ubara Y, Hara S, Ogura Y, Yamada A (1997) Association of Sjogren’s syndrome with hereditary angioneurotic edema: report of a case. Clin Immunol Immunopathol 84:95–97
Botto M, Walport MJ (2002) C1q, autoimmunity and apoptosis. Immunobiology 205:395–406
Ioannidis JP, Vassiliou VA, Moutsopoulos HM (2002) Long-term risk of mortality and lymphoproliferative disease and predictive classification of primary Sjogren’s syndrome. Arthritis Rheum 46:741–747
Conflict of Interest Statement:
None.
Author information
Authors and Affiliations
Corresponding author
Rights and permissions
About this article
Cite this article
Johnson, S., Hulton, SA., Brundler, MA. et al. End-stage renal failure in adolescence with Sjögren’s syndrome autoantibodies SSA and SSB. Pediatr Nephrol 22, 1793–1797 (2007). https://doi.org/10.1007/s00467-007-0526-y
Received:
Revised:
Accepted:
Published:
Issue Date:
DOI: https://doi.org/10.1007/s00467-007-0526-y

